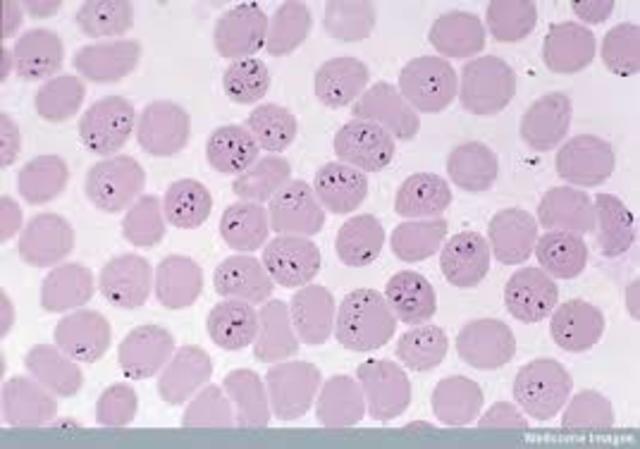
Malaria

-
-
William Harvey publishes An Anatomical Study of the Motion of the Heart and of the Blood in Animals, describing how blood is pumped throughout the body by the heart, and then returns to the heart and recirculates.
-
Anton van Leeuwenhoek refines the microscope and fashions nearly 500 models. Discovers blood cells and observes animal and plant tissues and microorganisms.
-
Edward Jenner develops a method to protect people from smallpox by exposing them to the cowpox virus. In his famous experiment, he rubs pus from a dairymaid's cowpox postule into scratches on the arm of his gardener's 8-year-old son, and then exposes him to smallpox six weeks later (which he does not develop). The process becomes known as vaccination from the Latin vacca for cow
-
Joseph Lister was convinced of the need for cleanliness in the operating room. He develops antiseptic surgical methods, using carbolic acid to clean wounds and surgical instruments
-
First vaccine for rabies
-
Emil von Behring discovers antitoxins and uses them to develop tetanus and diphtheria vaccines.
-
German physicist Wilhelm Conrad Roentgen discovers X rays
-
Ronald Ross demonstrates that malaria parasites are transmitted via mosquitoes
-
Paul Zoll develops the first cardiac pacemaker to control irregular heartbeat.
-
First vaccine for chicken pox.
Plan projects on a visual timeline
Map milestones, phases, deadlines, and key events in one place so the sequence is easier to see and share. Timetoast is a timeline maker for work, school, research, and stories.